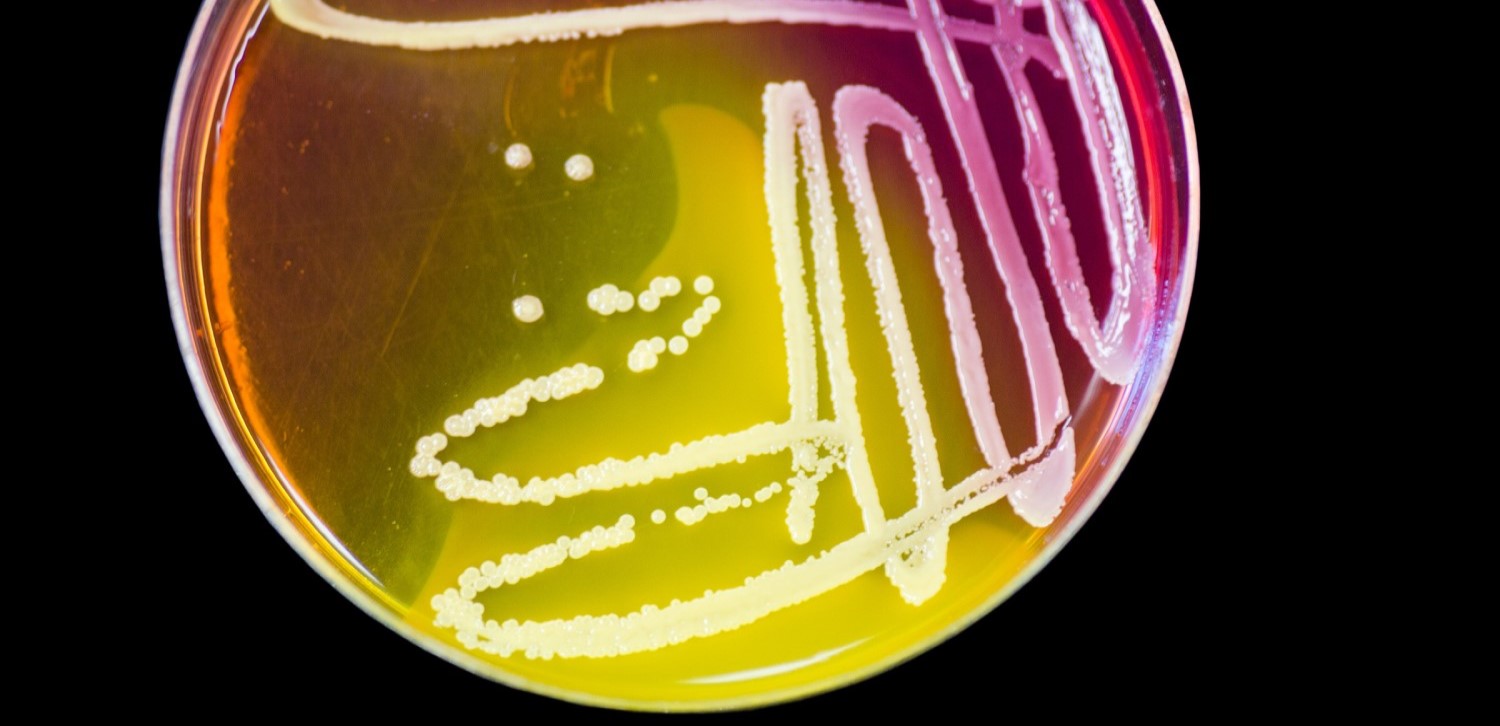

Waarom zijn bladeren eigenlijk groen en hoe komt het dat ze van kleur veranderen in de herst?
Category Archives: Plants
Cave Art on Drugs
The images in cave paintings were long believed to be strongly influenced by the consumption of hallucinogenic substances. New scientific findings have researchers question this theory.
Reforestation under the sea
Seagrass is among the most important marine plants, as it harbors whole ecosystems and also stores carbon dioxide. Areas in which these underwater meadows grow have declined drastically, US scientists started a reforestation campaign, to give endangered species a new habitat and to fight climate crisis.
Broad beans support bumblebee population
Bumblebees benefit from broad bean plants. By planting these crops, the declining bumblebee population can be increased again.
Decision making without a brain – The secret messengers of plants
How do you make decisions if you cannot think? How do you respond to danger if you cannot run or hide? Plants know the answer to these questions. And fundamental researchers all over the world try to understand them as well.
Unborn fruit
Laatst zag ik een klein glazen potje met iets behoorlijk bizars erin.
Sun cream for trees?!
Last month, in the Dutch town of Doetinchem, nature managers applied sun cream onto the bark of beech trees. Is that really necessary?
How knowledge of photosynthesis leads to production of clean energy.
From fundamental research to an application
Why scientists need to create GMOs for their research in the lab
Genetically modified organisms (GMOs) are powerful tools that help scientists study the foundation of life. The knowledge that can be created with them is the basis for applications everyone can benefit from. It can be the cure of a disease or the cure of hunger. The GMOs are made to be used in a laboratory, but the knowledge that is created with them is made for everyone.